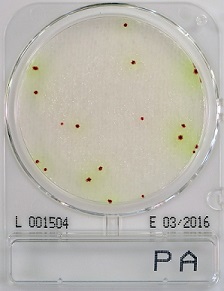

Compact Dry PA
- Gebrauchsfertige und leicht zu handhabende Platte: Die Vorbereitung des Mediums ist nicht erforderlich, wodurch die Verschwendung von Medium und Vorbereitung des Mediums entfällt.
- Der Nachweis von Kolonien auf der Platte ist einfach und eindeutig.
- Einzelne Kolonien auf der Platte können für weitere Identifizierungstests isoliert werden.
Gebrauchsfertige Petrischalen für die zuverlässige mikrobiologische Analyse auf Pseudomonas aeruginosa
Compact Dry PA ist ein Standard-Nähragar enthaltendes Medium zum Nachweis der Gattung Pseudomonas aeruginosa. Aufgrund des Redox-Indikators Tetrazolium-Salz weisen die Bakterienkolonien eine rote Färbung auf. Eine Unterscheidung von anderen Pseudomonaden erfolgt durch Ausbildung eines gefärbten Hofes um die Kolonie herum.
Incubation time and temperature: 45 - 51 hours at 34 - 36 °C
Shelf life: 12 months after manufacturing
Storage: Room temperature (+ 1 to + 30 °C)
Sample pretreatment
Viable count in water or liquid foodstuff
Drop 1 ml of specimen (dilute if necessary) in the middle of the Compact Dry plate.
Viable count in water using membrane filtration
Add 1 ml diluent, e.g. Peptone water or other appropriate diluent according to EN ISO 6887 in the middle of the plate. Filtrate 100 ml of water sample (or more e.g. 250 ml for bottled water) using a 47 mm diameter, sterile membra-ne with 0.45 µm pore size. Directly after the end of filtration apply the filter on the pre-moisturized Compact Dry plate. Take care that the filtration side is upwards.
Viable count in solid foodstuff
Add appropriate volume of buffer solution (e.g. PBS, 1 part solid foodstuff + 9 parts buffer) to the sample and homogenize using a stomacher® and suitable stomacher® bags. Drop 1 ml of homogenized sample (dilute if necessary) on the middle of the dry sheet of the Compact Dry plate.
Viable count in swab test specimen
Use the Compact Dry Swab offered by HyServe Id-No. 1 002 952/3 (40/240 pieces and wipe an appropriate area of the surface and put it back into the device with wiping solution. Shake the closed device vigorously. Drop 1 ml of wiping solution (dilute if necessary) the middle of the Compact Dry plate
Test instructions
1. Open the cap and drop 1 ml of specimen on the middle of the Compact Dry plate.
2. Specimen diffuses automatically and evenly into the sheet and transforms the dried sheet into a gel within seconds.
3. Put the cap again on the plate and write the information needed on the memorandum section.
4. Turn over the capped plate and put in the incubator. 5. After incubation count the number of colored colonies underneath the plate. White paper placed under the plate helps to count the colonies.